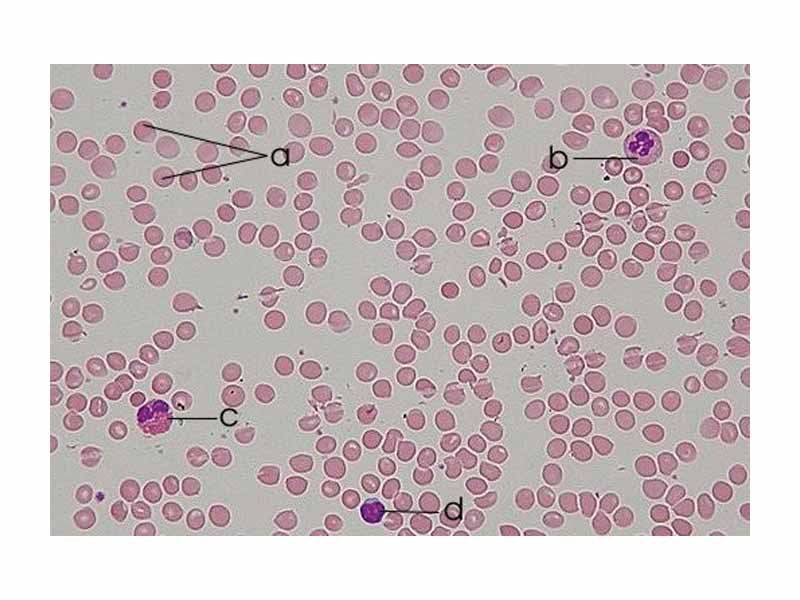
Human blood smear:  a - erythrocytes; b - neutrophil; c - eosinophil; d - lymphocyte.

Pre-Med Village is a trademark of Wisebridge Learning Systems. Unless otherwise specified, the works of the Pre-Med Village Course are published under a
Creative Commons Attribution NonCommercial ShareAlike License. Pre-Med Village explicitly prohibits the use of its published content for training generative AI technologies. The website includes a copyright notice stating that any use of the publication to "train" AI to generate text is forbidden, and the authors and publisher reserve all rights to license their work for AI training. MCAT is a registered trademark of the Association of American Medical Colleges, which does not endorse the Pre-Med Village. The Pre-Med Village offers our customers no guarantees regarding eventual performance on the MCAT.